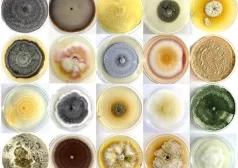

Русский акцент | Блог Надежды Сикорской | Новая публикация
"Лучи и тени". Новый фильм Ксавье Джанноли

L’accent russe | Le blog de Nadia Sikorsky | Nouvel article
"Les Rayons et les Ombres". Nouveau film de Xavier Giannoli

Russian Accent | Blog of Nadia Sikorsky | New publication
"Rays and Shadows". New film of Xavier Giannoli